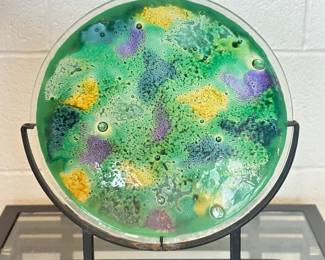

Part II The Jack Brandt Collection at Motoexotica in Fenton
Sale Starts
Sep 26
12amSale Ends
Oct 5
7pmTerms & Conditions
Effective 12/1/2021:
We will no longer be holding or transporting items after the scheduled pick up date. Any items left after the scheduled pick up are forfeited without refund. This applies to any location we offer auctions at, including our auction house in High Ridge. Multiple bidders per auction do not retrieve their items during the pick up time and we do not have the storage to hold items. Please do not bid if you cannot pick up your items.
Warning to non payers: You will be banned from all future auctions hosted by 2 Pickin Chicks and other auctioneers may ban you too. We have zero tolerance for bidders that sign up with prepaid cards and don't pay. Every auction we have multiple bidders that either not pay and/or not pick up their items. Please do your part and pay for items and pick up during the scheduled pick up.
NO SHOWS: If you do not show up for your items on the pick up date and fail to contact us prior to the auction ending, then you are still responsible for payment and forfeit the items. You may also be charged a removal fee for the items not picked up.
All bidders must complete online registration in order to bid in this auction and must be at least 18 years of age in order to bid. Once a bid is placed you are bound to this agreement and if you win the items you will be expected to complete all payment and shipping as stated in the T&C of the auction and follow all guidelines included on the site. All bidders are entering into a binding contract with 2 Pickin Chicks Auction once they bid, and are legally obligated to pay for all items won and adhere to all auction terms and conditions. 2 Pickin Chicks Auction Reserves the right to decline all and any bidder for any reason. We do not approve bidders with past no show, or no pay from other auction companies.
There will be no help to remove items upon pickup if that is bidder's method of item retrieval. Please be sure to bring help upon pickup of your items if needed as well as any packing materials for your merchandise. 2 Pickin Chicks Auction is not responsible for any accidents or injury that occur to winning bidders upon pickup of items won. It is winning bidders responsibility to safely remove all items won and not damage any surrounding structures or vehicles in parking spaces upon pickup. All items must be paid for and picked up as stated in the auction T&C
Payment is made through GlobalPayments within HiBid. All invoices are charged in full within 24 hours of the auction ending. If you wish to arrange a different form of payment then you must get approval PRIOR to the auction ending. Otherwise your card on file will be charged. No exceptions. Orders over $500 require photo ID at pick up to ensure credit card payment matches buyer.
It is at our discretion to add or remove items from this auction at any time.
Any items not picked up on pickup date will be considered abandoned. You will still be charged for all items not picked up via your credit card on file.
During the auction you can see your bid. Note that after auctions end you may not retract a winning bid for an item. Once the hammer drops you are responsible for payment of your items if you are the winning bidder.
We do not recommend that you put in your maximum bid if you are not able to follow closely the outcome of the items you are bidding on for the auction. This allows you to be in control of your items of interest during your busy personal schedule. When putting in your maximum online bid for an item it always stays at the lowest bid increment and only goes up when others bid against you.
Auction Closing: This auction will have a soft closing which means that items will begin closing at 7pm one at a time with another item closing every 20 seconds from one another. This way you can bid on multiple items at one time and not fear you may lose any of them. Bidding will be extended on an item for 1 minute if anyone bids on that item within the last 1 minute of items closing. This once again keeps other bidders from steeling an item from you when you have put your time and effort into getting it for several days/bids.
2 Pickin Chicks Auction reserves the right to extend, cancel, retract, ban or reschedule any item in this event. The auctioneer reserves the right to change, closing time if needed.
Due to this being an online auction, please keep in mind that connection server or other technology may suffer difficulties and effect your ability to bid. 2 Pickin Chicks Auction nor this service provider are not responsible for any technical issues that occur with the online auction process. Although we expect no delays or difficulties we cannot control the online world at play for the event.
2 Pickin Chicks
Description & Details
Internet-only. Auction runs 9/18/2025 through 10/5/2025. The first lot closes at 7 PM CST 10/5/2025, Sunday night. Lots are staggered by 11 seconds with a soft close.
Join us for Part II of the Jack Brandt Collection, combined with select pieces from Motoexotica, right here in Fenton, MO. Jack Brandt was a well-known interior designer who operated a high-end design shop in St. Louis, and many of the items in this sale originated from his collection and shop. As always, we strongly encourage bidders to review all photos and read lot descriptions carefully. Many items show wear, and unless otherwise noted, items have not been tested.
Lot location details: Lots 4–399: Main level and garage area of the warehouse Lots 400+: Located upstairs (stairs required for removal) Please note we are unable to load items for buyers—be sure to bring your own help and equipment.
**TWO DAY PICK UP: MONDAY 10/6/2025 from 10 AM to 2 PM and TUESDAY 10/7/2025 from 12 PM to 2 PM** Importance of Pickup Date and Time: The scheduled pickup date and time are set to ensure a smooth and efficient process for all bidders and the auction team. It is crucial that all items are picked up within the designated pickup window. Failure to pick up your items during the scheduled time will result in forfeiture of those items, as we cannot guarantee storage or access to the property after pickup ends. Please plan accordingly to avoid losing any purchases. You are welcome to send someone on your behalf to pick up your items.
IMPORTANT: ALL ITEMS ARE SOLD AS IS. We do not clean, repair, or improve items in any way. No refunds or returns will be issued. Items are not tested unless specifically noted in the title or description, and any testing must be done onsite during pickup. Once an item leaves the pickup location, all sales are final. If you have questions or need additional information about an item, please contact us before the auction ends. Otherwise, bring any concerns with you to pickup—we’re happy to assist you onsite.
Photo ID and signature may be required at pickup at any time, in accordance with credit card processing requirements. For orders over $100, both are required without exception.
Bidders are fully responsible for the safe and timely removal of all items during the designated pickup window. Any damage to the property during removal will be the financial responsibility of the bidder. Please bring appropriate tools if disassembly is required, and enough help to move large or heavy furniture. Refer to Lot 1 for important pickup information, including which floor items are located on and whether the home has a walkout basement or other accessibility details. This will help you plan accordingly for a smooth and safe pickup.
Invoices are typically emailed within one hour of the auction ending. If you don’t see yours, please check your spam or junk folder and add info@2pickinchicks.com to your safe sender list. Please note: we have no control over how emails are delivered or filtered on your end. You are fully responsible for receiving your invoice and picking up items during the scheduled time. Pickup dates and times are clearly listed in multiple locations, including the auction notice, Lot 1 & 2, and your invoice. If you have questions or need another copy of your invoice, contact Heather—texting is preferred at 636-346-3493. Any time you see "WON" or "MAY HAVE WON" next to an item, that means you won and will receive an invoice. Keep an eye out, and don’t hesitate to reach out if you're having issues.
Bidders are responsible for verifying all items onsite before leaving. Each bidder is provided with a copy of their invoice at pickup. It is your responsibility to ensure you collect all of your items before leaving. Pickup can be busy, so we strongly recommend checking off each item on your invoice as you load them. Once the pickup window closes, any unclaimed items will be considered forfeited. Items listed as "working" or "tested" must be tested onsite. No refunds will be issued once items leave the property or after pickup ends. Thank you for your cooperation!
12% Buyer’s Premium. Happy bidding!

Thank you for using EstateSales.NET. You're the best!